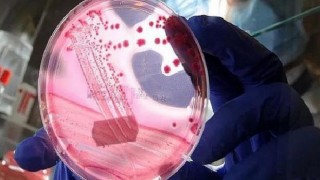
Yeni kanser ilacı Van’dan Türkiye’ye dağıtılacak

İstanbul Büyükşehir Belediyesi Kültür Daire Başkanlığı’nın düzenlediği “25 Kasım Kadına Yönelik Şiddetle Uluslararası Mücadele Günü Etkinlikleri”nin bir parçası olarak, İBB Şehir Tiyatroları’na bağlı Çağdaş Gösteri Sanatları Merkezi (ÇGSM), Mor Çatı Sığınağı Vakfı’yla birlikte bir okuma tiyatrosu, söyleşi ve atölye gerçekleştirilecek.
İBB Şehir Tiyatroları Çağdaş Gösteri Sanatları Birimi bünyesinde Emre Koyuncuoğlu ve Cemre Baytok; Mor Çatı Kadın Sığınağı Vakfı’nın hazırladığı "Kadına Yönelik Şiddet Deneyimleri" ve "Şiddete Karşı Anlatılar" kitaplarından bir derleme oluşturdu.
Derlemenin içinde yer alan, şiddete karşı kadınların verdiği mücadelenin aktarıldığı gerçek hikâyeler; Aslı İçözü ve Lerzan Pamir rejisinde, İBB Şehir Tiyatroları oyuncularından Bennu Yıldırımlar, Sevinç Erbulak, Sevil Akı, Ebru Üstüntaş, Hazal Uprak’ın rol aldığı bir okuma tiyatrosu olarak izlenebilecek.
Ardından “kadına yönelik şiddete karşı” çözüm üretme üzerine alan deneyimi olan Cemre Baytok ve “kadına yönelik şiddet” hakkında Şehir Tiyatroları’nda aktif çalışmalar yürüten tiyatronun yönetmenlerinden Lerzan Pamir, Emre Koyuncuoğlu, Aslı İçözü ve Mor Çatı Kadın Sığınağı Vakfı’ndan Zuhal Güreli ile bir sohbet gerçekleştirecek.
Sohbet, seyircilerin doğrudan etkileşim kurabileceği bir yapıda olacak. Katılımcılar okuma tiyatrosundaki hikâyeler üstünden, farklı disiplinlerin ve farklı alanların katılımıyla, “şiddete karşı” birbirlerini nasıl güçlendirdiklerini izleyiciyle paylaşacaklar.
Kadın sanatçılarımızın katkısıyla birlikte “güçlenme” önerisi taşıyan etkinlikler, 1 Aralık Çarşamba saat 13.00’te Ümraniye Kültür Merkezi’nde, 7 Aralık Salı saat: 13.00’te Fatih Kültür Merkezi’nde düzenlenecek.
Farkındalık Broşürü
Ayrıca İBB Şehir Tiyatroları, farkındalık yaratmak adına “Şiddet, Taciz ve Mobbing’i Önlemek için Aydınlatma Broşürü” hazırladı. Broşürde cinsel taciz, cinsel saldırı, çocuğa yönelik cinsel istismar, mobbing, kötü muamele konularına yönelik aydınlatıcı bilgiler yer alıyor.
Program
Okuma Tiyatrosu
“Şiddete Karşı Güçlenme Anlatıları”
Yöneten: Aslı İçözü, Lerzan Pamir
Okuyan: Bennu Yıldırımlar, Sevinç Erbulak, Sevil Akı, Ebru Üstüntaş, Hazal Uprak
Söyleşi
“Şiddete Karşı Çok Disiplinli Öneriler”
Cemre Baytok, Emre Koyuncuoğlu, Lerzan Pamir ve Zuhal Güreli İle
Kaynak: (BHA) - Beyaz Haber Ajansı

Yorum Yazın